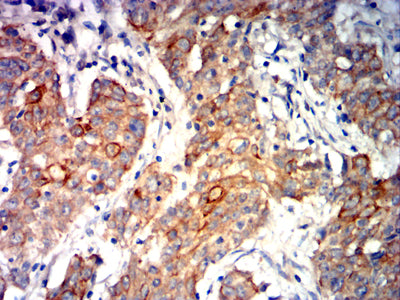

Mouse Monoclonal Antibody to CDH1
Description |
|---|
This gene encodes a classical cadherin of the cadherin superfamily. Alternative splicing results in multiple transcript variants, at least one of which encodes a preproprotein that is proteolytically processed to generate the mature glycoprotein. This calcium-dependent cell-cell adhesion protein is comprised of five extracellular cadherin repeats, a transmembrane region and a highly conserved cytoplasmic tail. Mutations in this gene are correlated with gastric, breast, colorectal, thyroid and ovarian cancer. Loss of function of this gene is thought to contribute to cancer progression by increasing proliferation, invasion, and/or metastasis. The ectodomain of this protein mediates bacterial adhesion to mammalian cells and the cytoplasmic domain is required for internalization. This gene is present in a gene cluster with other members of the cadherin family on chromosome 16. |
References |
|---|
| 1,PLoS One. 2020 Apr 29;15(4):e0232429. 2,Gene. 2020 Sep 5;754:144899. |
Specification |
|
|---|---|
| Aliases | UVO; CDHE; ECAD; LCAM; Arc-1; BCDS1; CD324;E-cadherin;E cadherin |
| Entrez GeneID | 999 |
| Swissprot | P12830 |
| clone | 6C2A10 |
| WB Predicted band size | 97.5kDa |
| Host/Isotype | Mouse IgG1 |
| Antibody Type | Primary antibody |
| Storage | Store at 4°C short term. Aliquot and store at -20°C long term. Avoid freeze/thaw cycles. |
| Species Reactivity | Human, Mouse, Rat |
| Immunogen | Purified recombinant fragment of human CDH1 (AA:extra(155-354)) expressed in E. Coli. |
| Formulation | Purified antibody in PBS with 0.05% sodium azide |
Application |
|
|---|---|
| WB | 1/500 - 1/2000 |
| IHC | 1/200 - 1/1000 |
| IF | 1/200 - 1/1000 |
| FCM | 1/200 - 1/400 |
| ELISA | 1/10000 |
Product Image
-
Black line: Control Antigen (100 ng);Purple line: Antigen (10ng); Blue line: Antigen (50 ng); Red line:Antigen (100 ng)

-
Western blot analysis using CDH1 mouse mAb against PC-3 (1), A431 (2), MCF-7 (3), HT-29 (4), HePG2 (5), C6 (6), A549 (7), NIH/3T3 (8), and C2C12 (9) cell lysate.

-
Immunofluorescence analysis of Hela cells using CDH1 mouse mAb (green). Blue: DRAQ5 fluorescent DNA dye. Red: Actin filaments have been labeled with Alexa Fluor- 555 phalloidin. Secondary antibody from Fisher (Cat#: 35503)

-
Flow cytometric analysis of Hela cells using CDH1 mouse mAb (green) and negative control (red).

-
Flow cytometric analysis of HepG2 cells using CDH1 mouse mAb (green) and negative control (red).

-
Flow cytometric analysis of HT-29 cells using CDH1 mouse mAb (green) and negative control (red).

-
Immunohistochemical analysis of paraffin-embedded human endometrial cancer tissues using CDH1 mouse mAb with DAB staining.

-
Immunohistochemical analysis of paraffin-embedded human stomach cancer tissues using CDH1 mouse mAb with DAB staining.

鄂公网安备42018502007531号
鄂公网安备42018502007531号

